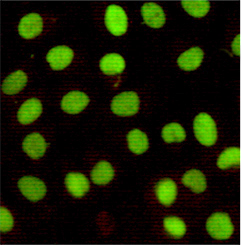

-
Product Name
Anti-Ku80 (5C5) Mouse antibody
- Documents
-
Description
Ku80 (5C5) Mouse monoclonal antibody
-
Tested applications
WB, IHC-P, ICC/IF, FC, IP
-
Species reactivity
Human, Mouse
-
Isotype
Mouse IgG1
-
Preparation
Antigen: Purified recombinant fragment of human XRCC5 expressed in E. Coli.
-
Clonality
Monoclonal
-
Formulation
Ascitic fluid containing 0.03% sodium azide.
-
Storage instructions
Store at 4°C short term. Store at -20°C long term. Avoid freeze / thaw cycle.
-
Applications
WB: 1/500 - 1/2000
IHC: 1/200 - 1/1000
ICC: 1/200 - 1/1000
FC: 1/200 - 1/400
ELISA: 1/10000
-
Validations

Western blot detection of Ku80 in A549,MCF7 and Hela cell lysates using Ku80 mouse mAb (dilution 1:500).Predicted band size:86KDa.Observed band size:86KDa.

Immunoprecipitation analysis of Hela cell lysates using XRCC5 antibody.
Immunocytochemistry of HeLa cells using Ku80 mouse mAb (dilution 1:100).
-
Background
Swiss-Prot Acc.P13010.The protein encoded by this gene is the 80-kilodalton subunit of the Ku heterodimer protein which is also known as ATP-dependant DNA helicase II or DNA repair protein XRCC5. Ku is the DNA-binding component of the DNA-dependent protein kinase, and it functions together with the DNA ligase IV-XRCC4 complex in the repair of DNA double-strand break by non-homologous end joining and the completion of V(D)J recombination events. This gene functionally complements Chinese hamster xrs-6, a mutant defective in DNA double-strand break repair and in ability to undergo V(D)J recombination. A rare microsatellite polymorphism in this gene is associated with cancer in patients of varying radiosensitivity.
Related Products / Services
Please note: All products are "FOR RESEARCH USE ONLY AND ARE NOT INTENDED FOR DIAGNOSTIC OR THERAPEUTIC USE"
